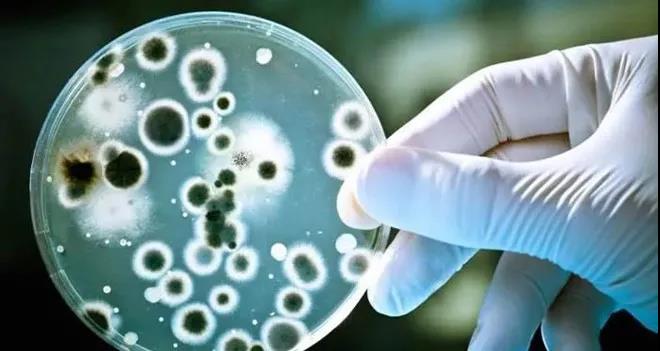
全球水污染现状

我们关注世界水质,更专注家庭用水健康
访问次数: | 作者:LUOENSI | 标签:
全球水污染现状
目前,全世界每年约有4200多亿m3(3立方米)的污水排入江河湖海,污染了5.5万亿m3的淡水,这相当于全球径流总量的14%以上。

第四届世界水论坛提供的联合国水资源世界评估报告显示,全世界每天约有数百万吨垃圾倒进河流、湖泊和小溪,每升废水会污染8L淡水;所有流经亚洲城市的河流均被污染;美国40%的水资源流域被加工食品废料、金属、肥料和杀虫剂污染;欧洲55条河流中仅有5条水质勉强能用。
水污染对人类健康造成很大危害。发展中国家约有10亿人喝不清洁水,每年约有2500多万人死于饮用不洁水,全世界平均每天5000名儿童死于饮用不洁水,约1.7亿人饮用被有机物污染的水,3亿城市居民面临水污染。在肝癌高发区流行病的调查表明,饮用藻茵类毒素污染的水是肝癌的主要原因。

近几年3月21日的世界水日,联合国发布的资料表明:目前全球有11亿人缺乏安全饮用水,每年有500多万人死于同水有关的疾病。据联合国环境规划署预计,今天世界上将有1200万人死于水污染和水资源短缺。如果人类改变目前的消费方式,到2025年全球将有50亿人生活在用水难以完全满足的地区,其中25亿人将面临用水短缺。由于人们饮用了被污染的水,这正是人得病,甚至传染的主要起因之一。
水污染对身体的危害情况
据有关报道,发展中国家中估计有半数人,不是由于饮用被污染的水或食物直接受感染,就是由于带菌生物(带病煤)如水中孳生的蚊子间接感染,而罹患与水和食品关联的疾病。这些疾病中最普遍且对人类健康状况造成影响最大的疾病是腹泻病、疟疾、血吸虫病、登革热、肠内寄生虫感染和河盲病(盘尾丝虫病)。联合国教科文组织发布的数据显示,大约80%的类疾病是由质量低劣的饮用水造成的。世界卫生组织估计,仅仅饮用了不安全的水以及缺乏卫生用水而得的疾病,每年死亡的总人数在500万人以上。
我们专注净水 更关注家庭用水健康
深圳市洛恩斯科技有限公司,隶属于德国LUOENSI环境集团旗下高端净化系统品牌,公司致力于智能水处理设备及智能健康家电的研发、生产和销售,是国家级高新技术示范企业,国际公认的最大水处理设备制造商,是最具有价值的国际净化品牌,被誉为国际净化系统专家。
洛恩斯创建于20世纪中期,秉承“以用户需求为出发点,智造精品,普及大众,为客户创造价值”的产品理念,经过70多年的努力,洛恩斯全屋净水为广大家庭的提供多种健康饮水方案,成为净水行业的品牌标杆。洛恩斯1968年首次提出“全屋净水系统”,早已形成了一套完整、成熟的家庭净水系统,为人们的生活带来洁净与健康。

目前,洛恩斯拥有世界上先进的太空净水黑科技,以及各国认证的专利核心技术,生产区设有智能化生产线,打造高级无尘车间。1000余家洛恩斯全屋净水旗舰店覆盖全国,将净水送进每家每户。未来,洛恩斯将持续倾心打造适合各区域水质产品, 占领行业发展先机,顺应大健康产业发展趋势,让世界每个家庭都能拥有洁净健康的生活环境。



















